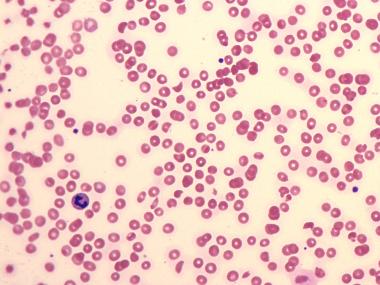
Hemolytic uremic syndrome: हेमोलिटिक यूरेमिक सिंड्रोम क्या है?

परिचय-
हेमोलिटिक यूरीमिक सिंड्रोम या (HUS),किडनी से संबंधित बीमारी है ये तब होता है जब रेड ब्लड सेल खत्म हो जाता हैं और किडनी के फिल्टर प्रणाली को ब्लॉक कर देता हैं। रेड ब्लड सेल में हीमोग्लोबिन होता है जो लोहे से भरपूर प्रोटीन ब्लड को लाल रंग देता है और लंग्स से शरीर के सभी भागों में ऑक्सीजन पहुंचाता है।
जब किडनी और ग्लोमेरुली (glomeruli) – किडनी के अंदर जहां ब्लड को फिल्टर किया जाता है वहां क्षतिग्रस्त रेड ब्लड सेल से भरा होता है, वे अपना काम करने में असमर्थ होते हैं। यदि किडनी काम करना बंद कर दे तो एक बच्चा किडनी की गंभीर चोट को विकसित कर सकता है – किडनी का अचानक अस्थायी नुकसान Hemolytic uremic syndrome बच्चों में तेजी से किडनी की चोट का सबसे आम कारण है।
कारण के आधार पर HUS के लक्षण अलग हो सकते हैं। HUS के ज्यादातर मामले E कोलाई बैक्टीरिया के कुछ उपभेदों के संक्रमण के वजह से होता हैं, जो पहले डाइजेस्टिव तंत्र को प्रभावित करते हैं।
HUS के इस रूप के प्रारंभिक संकेत और लक्षण शामिल हो सकते हैं:
1-दस्त, जो अक्सर खूनी होता है
HUS के सभी रूप में कोई कारण नही है बल्कि ब्लड को नुकसान पहुंचा सकता है। यह क्षति रेड ब्लड सेल को टूटने (एनीमिया), ब्लड वाहिकाओं में ब्लड क्लोट और किडनी की क्षति का कारण बनता है। इन परिवर्तनों के लक्षण में शामिल हैं-
1-पीला रंग, जिसमें गालों में गुलाबी रंग की कमी और कम पलकें शामिल हैं।
2-अत्यधिक थकान
4-आसान चोट या अस्पष्टीकृत खरोंच
5-असामान्य रक्तस्राव, जैसे कि नाक और मुंह से खून बहना
6-पेशाब में कमी या खून आना
7-पैरों और चेहरे, हाथ, पैर या पूरे शरीर में सूजन आना
8-भ्रम, दौरे या आघात
9-हाई ब्लड प्रेसर
डॉक्टर को कब दिखाना चाहिए-
अगर आपको या आपके बच्चे को खूनी दस्त या दस्त का अनुभव होता है, तो अपने डॉक्टर को तुरंत दिखाएं:
1-मूत्र उत्पादन में कमी
2-सूजन
3-अस्पष्टीकृत खरोंच
4-असामान्य रक्तस्राव
6-यदि आप या आपका बच्चा 12 घंटे या अधिक समय तक पेशाब नहीं करता है तो आपातकालीन देखभाल की तलाश करें।
यह भी पढ़ें: मेनोपॉज और हृदय रोग : बढ़ती उम्र के साथ संभालें अपने दिल को
HUS होता है जहां एक इम्यून सिस्टम ब्लड सेल को खत्म कर देता है। यह कम रेड ब्लड सेल के स्तर, कम प्लेटलेट स्तर और किडनी की चोट के परिणामस्वरूप होता है।
बच्चों में HUS
बच्चों में HUS का सबसे आम कारण एस्चेरिचिया (Escherichia) कोलाई (E. coli) से संक्रमण है। ई- कोलाई के कई रूप है जो ज्यादा समस्याएं पैदा नहीं करती हैं। वास्तव में, ई-कोलाई बैक्टीरिया सामान्य रूप से स्वस्थ लोगों और जानवरों की आंतों में पाया जाता है। हालांकि, ई-कोलाई दूषित भोजन से गुजरते हैं जो संक्रमण के लिए जिम्मेदार हैं जो HUS को जन्म देते हैं। अन्य बैक्टीरिया जैसे शिगेला पेचिश (Shigella dysenteriae) और साल्मोनेला टाइफी (Salmonella typhi) HUS पैदा कर सकता हैं।
वयस्कों में HUS
वयस्कों में HUS भी ई- कोलाई के संक्रमण से उत्पन्न होता हैं जिसमें कई गैर-बैक्टीरियल कारण भी हैं जो आम हैं, जिनमें शामिल हैं:
1-गर्भावस्था
2-एचआईवी / एड्स संक्रमण
3-कुनैन (मांसपेशियों में ऐंठन के लिए प्रयुक्त)
4-कीमोथेरेपी और इम्यूनोसप्रेसेन्ट दवा
6-विरोधी प्लेटलेट दवाओं
7-कैंसर
8-प्रणालीगत एक प्रकार का वृक्ष और ग्लोमेरुलोनेफ्राइटिस
यह भी पढ़ें: डायबिटीज के साथ बच्चे के जीवन को आसांन बनाने के टिप्स
HUS ई-कोलाई बैक्टीरिया के कुछ उपभेदों के संक्रमण के कारण होता हैं। ई-कोलाई के संपर्क में आने पर हो सकता है:
2-पूल या झीलों में तैरना मल से दूषित होता है
3-संक्रमित व्यक्ति के साथ निकट संपर्क रखें, जैसे कि परिवार या बच्चे की देखभाल वाले केंद्र पर।
हेमोलिटिक यूरेमिक सिंड्रोम के विकास का जोखिम सबसे अधिक है:
1-5 साल या उससे कम उम्र के बच्चे
2-65 वर्ष या उससे अधिक उम्र के वयस्क
3-जिन लोगों का इम्यून सिस्टम कमजोर होता है
4-कुछ आनुवंशिक परिवर्तनों वाले लोग जो उन्हें HUS के प्रति अधिक संवेदनशील बनाते हैं।
यह भी पढ़ें: World Immunisation Day: बच्चों का वैक्सीनेशन कब कराएं, इम्यून सिस्टम को करता है मजबूत
हेमोलिटिक यूरेमिक सिंड्रोम के सामान्य उपचार में शामिल हैं:
द्रव प्रतिस्थापन (Fluid Replacement)
हेमोलिटिक यूरेमिक सिंड्रोम के लिए प्रमुख उपचार द्रव प्रतिस्थापन है ये उपचार इलेक्ट्रोलाइट्स को बदल देता है जिसमें शरीर के काम करने की जरुरत होती है। इलेक्ट्रोलाइट्स कैल्शियम, पोटेशियम और मैग्नीशियम जैसे खनिज हैं। द्रव प्रतिस्थापन भी किडनी के माध्यम से ब्लड के प्रवाह को बढ़ाता है आपके डॉक्टर अंतःशिरा तरल पदार्थ (Intravenous fluids) देगा, लेकिन आपको अधिक पानी या इलेक्ट्रोलाइट पीने से भी तरल पदार्थ का सेवन बढ़ाने के लिए प्रोत्साहित कर सकता है।
रक्त – आधान (Blood Transfusion)
यदि आपको आरबीसी का निम्न स्तर है, तो रेड ब्लड ट्रांसफ्यूशन होता है, ये ट्रांसफ्यूशन हॉस्पिटल में होता हैं। ट्रांसफ्यूशन आरबीसी के काउंट्स से जुड़े लक्षणों को दूर करता है, जैसे कि सांस की तकलीफ और अत्यधिक थकान।
ये लक्षण एनीमिया के अनुरूप हैं जो ऐसी स्थिति उत्पन्न करता है जिसमें आपका शरीर मेटाबोलिज्म के लिए ऑक्सीजन के साथ शरीर के अंगों को पूरा करने के लिए रेड ब्लड सेल का उत्पादन नहीं कर सकता है। यह आरबीसी के नुकसान का कारण है।
अन्य उपचार
आपको डॉक्टर कोई भी दवाई खाने से मना कर सकता है जो कि HUS का कारण हो सकता है। यदि आपकी प्लेटलेट गिनती में कम है तो प्लेटलेट ट्रांसफ्यूसन आवश्यक हो सकता है।
प्लाज्मा विनिमय उपचार का दूसरा रूप है, जिसमें डॉक्टर डॉनर से ब्लड को प्लाज्मा के साथ प्लाज्मा में बदल देता है। आप स्वस्थ, नए रेड ब्लड सेल और प्लेटलेट्स के संचालन का समर्थन करने के लिए प्लाज्मा प्राप्त करता है।
यह भी पढ़ें: पाकिस्तान के पूर्व पीएम नवाज शरीफ लड़ रहे हैं जिंदगी से जंग, प्लेटलेट्स में हुई भारी कमी
यदि आपका किडनी विफल हो जाए, तो आपके शरीर से अपशिष्ट को फिल्टर करने के लिए किडनी डायलिसिस का उपयोग किया जाता है। यह एक अस्थायी उपचार है जब तक कि किडनी सामान्य रूप से काम नहीं करता। यदि ये सामान्य काम नहीं करता हैं, तो आपको किडनी प्रत्यारोपण की आवश्यकता हो सकती है।
दीर्घकालिन जटिलताएं-
HUS की मुख्य जटिलता किडनी की विफलता है। हालांकि, HUS भी कारण हो सकता हैं:
1-हाई ब्लड प्रेसर
2-अग्नाशयशोथ (pancreatitis)
3-बदली हुई मानसिक स्थिति
4-बरामदगी (seizures)
5-कार्डियोमायोपैथी (cardiomyopathy)
6-आघात (stroke)
7-प्रगाढ़ बेहोशी
अधिकतर लोग HUS से पूरे तरीके से ठीक हो चुके हैं।
हेमोलिटिक यूरेमिक सिंड्रोम को कैसे रोके?
HUS का सबसे आम कारण संक्रमण है। हालांकि आप इन जीवाणुओं से पूरी तरह नहीं बच सकते हैं, आप अपने संक्रमण के जोखिम को कम कर सकते हैं:
और पढ़ें:-
क्या हार्मोन डायट से कम हो सकता है मोटापा?
डायट, वर्कआउट के साथ फिटनेस मिशन बनाकर कम किया मोटापा
जानिए ब्रेन स्ट्रोक के बाद होने वाले शारीरिक और मानसिक बदलाव
ब्रेन स्ट्रोक की बीमारी शरीर के किस अंग को सबसे ज्यादा डैमेज करती है?
डिस्क्लेमर
हैलो हेल्थ ग्रुप हेल्थ सलाह, निदान और इलाज इत्यादि सेवाएं नहीं देता।
Hemolytic uremic syndrome. https://www.ncbi.nlm.nih.gov/pmc/articles/PMC4523989/. accessed on 04 Mar 2020
Hemolytic uremic syndrome. https://www.niddk.nih.gov/health-information/kidney-disease/children/hemolytic-uremic-syndrome. accessed on 04 mar 2020
Hemolytic uremic syndrome. https://www.mayoclinic.org/diseases-conditions/hemolytic-uremic-syndrome/symptoms-causes/syc-20352399. accessed on 04 Mar 2020
Hemolytic uremic syndrome. https://www.healthline.com/health/hemolytic-uremic-syndrome#diagnosis. accessed on 04 Mar 2020
Current Version
12/04/2020
Poonam द्वारा लिखित
के द्वारा मेडिकली रिव्यूड डॉ. प्रणाली पाटील
Updated by: Niharika Jaiswal